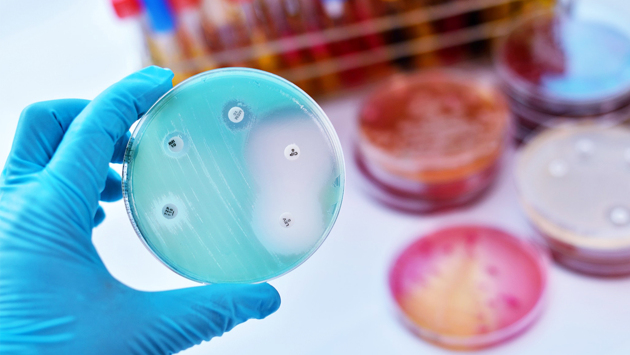
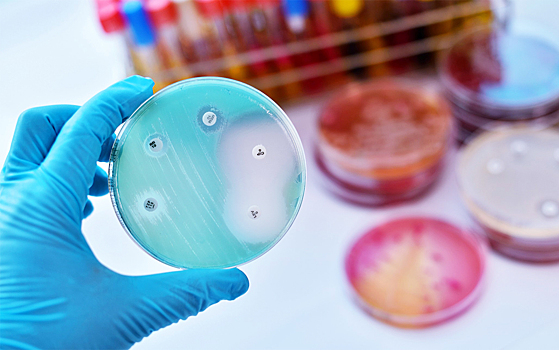
Резистентность: зачем она?

Резистентность: зачем она?
Биоинформатик Надежда Потапова расскажет все об устойчивости бактерий к антибиотикам, как она появляется, как ее можно предсказывать и предотвращать ее распространение и какие еще примеры устойчивости встречаются у растений и животных. Понравился материал? Добавьте Indicator.Ru в «Мои источники» Яндекс.Новостей и читайте нас чаще. Подписывайтесь на Indicator.Ru в соцсетях: Facebook, ВКонтакте, Twitter, Telegram, Одноклассники.